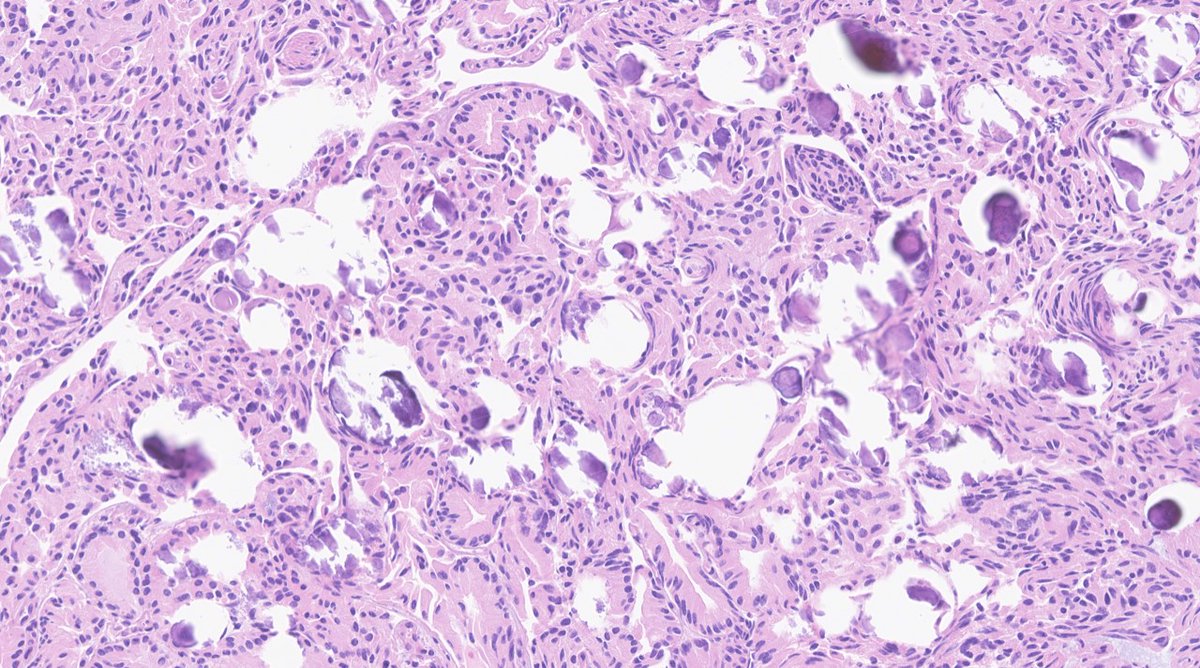

Mustafa Erdem Arslan, MD, FACP
@mearslanmd
Faculty @ecu_pathology Former Gastrointestinal Pathology Fellow @MSKPathology Former AP/CP and Chief Resident @albanymed #GIPath
ID: 1285392641128124416
https://www.researchgate.net/profile/Mustafa_Erdem_Arslan 21-07-2020 01:54:29
218 Tweet
906 Followers
661 Following

Forget not to apply for #PBPS abstract award submission. Win cash prize & get recognized at #USCAP2023! Deadline: Feb 6th. Submit your abstract here pbpath.org/abstract-submi… Olca Basturk Michelle Reid MD Diana Agostini-Vulaj Monika Vyas Vish Killari MD MPH Pooja Navale MD Abdul Abid Vidya Arole


We hope that Memorial Sloan Kettering Cancer Center would offer support for #Turkey_earthquake and #Syria_earthquake as well. Ahmet Dogan Gamze Gokturk Ozcan, MD Canan Firat, MD Hulya Sahin Ozkan Irem Sahver Isgor Hikmat Al Ahmadie @NoraKatabi Ahmet Zehir




Best way to be aware of what is new in #pancreatobiliary #pathology. Thanks Pancreatobiliary Pathology Society

The #PBPS Companion Society meeting #USCAP2023 is on March [email protected] AM CST. It's a session you don't want to miss - Diagnostic pearls & pitfalls in interp of small bxs and FS of #pancreatobiliary tract. See you all there! Vikram Deshpande Olca Basturk Diana Agostini-Vulaj


Monday PM 1:45-2:00pm Liver Pathology Platform Session (CC Room 217) #USCAP2023 Dr. Mustafa Arslan MSK Department of Pathology & Laboratory Medicine presents: “Undifferentiated Embryonal Sarcomas of the Liver: Analysis of 18 Adults Cases” #gipath





Nearing the end of a stellar year with OncSurgPath & Subspecialty #pathology fellows MSK Department of Pathology & Laboratory Medicine - thank you for your dedication, congrats 🥳on graduation, & all the best in your next steps!! Sahar J Farahani Rufaida Waqfi Gagandeep Kaur Lorraine Colón Cartagena Theodore Vougiouklakis, MD Bea Caraballo